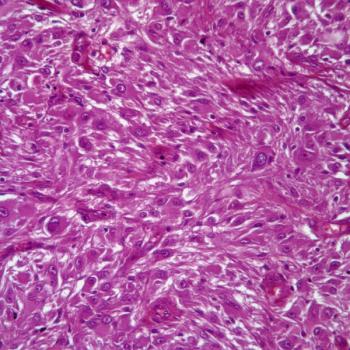

A progression-free survival benefit was seen in those with TP53 wild-type advanced/recurrent endometrial cancer who were treated with selinexor maintenance regardless of microsatellite instability status.

Your AI-Trained Oncology Knowledge Connection!


Hayley Virgil is a senior editor with CancerNetwork. When she isn't traveling to conferences and championing health equity in the oncology space, she can be found hiking, foraging wild plants, gardening, sewing ballgowns, practicing embroidery, or playing video games.

A progression-free survival benefit was seen in those with TP53 wild-type advanced/recurrent endometrial cancer who were treated with selinexor maintenance regardless of microsatellite instability status.

Camrelizumab and rivoceranib appear to be an appropriate novel, first-line regimen for unresectable hepatocellular carcinoma.

Confirmatory results from the phase 3 PAPILLON study further support the FDA approval of amivantamab-vmjw for patients with locally advanced/metastatic EGFR exon 20 insertion–mutant non–small cell lung cancer.

Findings from the phase 3 DESTINY-Breast04 trial supported the approval of fam-trastuzumab deruxtecan-nxki for HER2-low breast cancer in China.

The supplemental new drug application for zanubrutinib and obinutuzumab in patients with relapsed/refractory follicular lymphoma is supported by data from the phase 2 ROSEWOOD trial.
The FDA fast track designation for paxalisib and radiotherapy for PI3K-mutant solid tumor brain metastases is supported by data from a phase 1 study.

ERAS-801 is under investigation as part of the phase 1 THUNDERBBOLT-1 trial in a population of patients with EGFR-mutant, recurrent glioblastoma.

Black patients appear less likely than their White or Asian counterparts to meet hematologic lab criteria and treatment-related criteria necessary to enroll in clinical multiple myeloma trials.

Patients with HRR-mutant metastatic castration-resistant prostate cancer can now receive treatment with talazoparib and enzalutamide following the regimen’s approval by the FDA.

Most treatment-related adverse effects were low-grade following treatment with BMS-986158 plus ruxolitinib or fedratinib in a population of patients with intermediate- or high-risk myelofibrosis.

Additionally, treatment with sacituzumab govitecan-hziy may result in a prolonged overall response rate and clinical benefit rate vs treatment of physician’s choice in pretreated, endocrine-resistant, hormone receptor–positive, HER2-negative metastatic breast cancer.

Findings from the phase 3 NAPOLI 3 trial support NALIRIFOX as a novel reference regimen for first-line metastatic pancreatic ductal adenocarcinoma.

Ropeginterferon alfa-2b-njft has been moved to preferred status in the National Comprehensive Cancer Network guidelines for polycythemia vera based on data supporting the agent’s superior efficacy and safety in high- and low-risk populations.

18F-Fluorestradiol is currently the only imaging agent approved by the FDA for assessing estrogen receptor–positive lesion status to better guide treatment decision-making.

Claudin 18.2–targeting antibody-drug conjugate ATG-022 is under assessment as part of the phase 1 CLINCH study in patients with advanced or metastatic solid malignancies.

The FDA also accepts a premarket approval application for the Lumicell Direct Visualization System in the breast cancer space.

Investigators indicate that more analyses are necessary to identify patients with pretreated small cell lung cancer who will best benefit from treatment with olaparib and durvalumab.

PYX-201 is currently being investigated in a phase 1 trial in patients with solid tumors.

The CAR T-cell product has a neoantigen-specific T-cell receptor that is located and classified via a T-cell receptor discovery platform.

xT CDx is a 648-gene next-generation sequencing panel capable of determining microsatellite instability status in patients with colorectal cancer.

An update to the ASTRO and ESTRO clinical guidelines highlights the importance of a multidisciplinary approach to treating oligometastatic non–small cell lung cancer.

Patients with curable metastatic cancer appear to have long-lasting improvements in depression symptoms 8 weeks after a single treatment with psilocybin therapy.

Investigators report that patients with advanced or metastatic esophageal squamous cell carcinoma may have superior overall survival benefit following treatment with tislelizumab/chemotherapy vs placebo/chemotherapy.

The phase 3 SPLASH trial will assess the benefit of 177Lu-PNT2002 in patients with PSMA-expressing metastatic castration-resistant prostate cancer.

Patients with locally advanced unresectable or metastatic gastric or gastroesophageal junction adenocarcinoma may experience significant survival benefit following treatment with zolbetuximab.

Patients with platinum-resistant high-grade serous carcinoma have little overall survival benefit with the addition of vistusertib to weekly paclitaxel.

Patients with advanced well-differentiated/dedifferentiated liposarcoma may experience a positive progression-free rate following treatment with sitravatinib.

Investigators say that liposomal irinotecan plus fluorouracil and leucovorin should be considered as a treatment option for second-line, previously treated metastatic biliary tract cancer.

Overall survival and progression-free survival appear comparable in patients with relapsed small cell lung cancer treated with liposomal irinotecan vs topotecan.

Lifestyle choices such as diet and exercise can be useful in managing symptom burden and may even have an impact on some treatment outcomes, according to a director of Lifestyle Medicine from Massachusetts General Hospital.